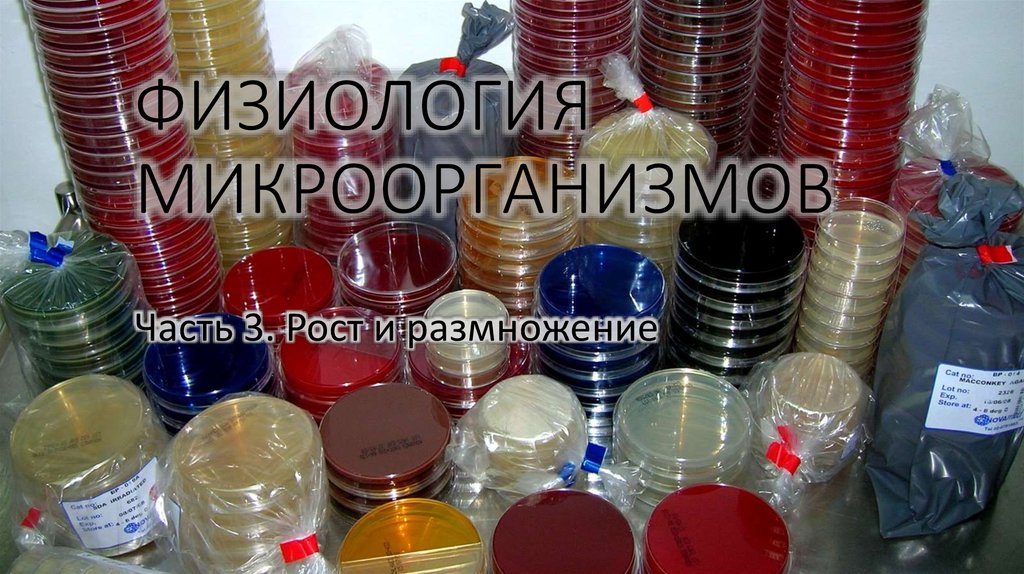
ФИЗИОЛОГИЯ МИКРООРГАНИЗМОВ
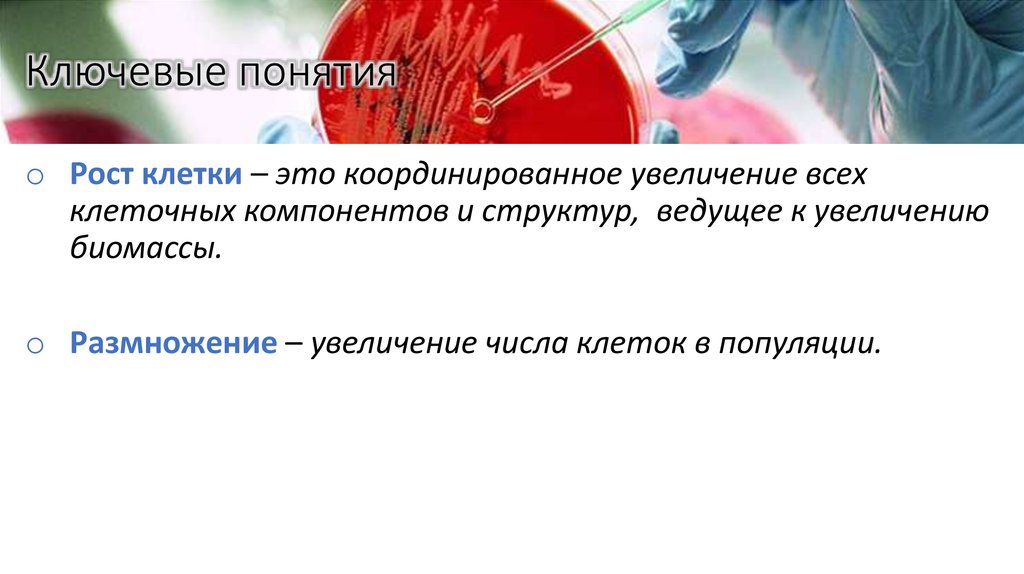
Ключевые понятия
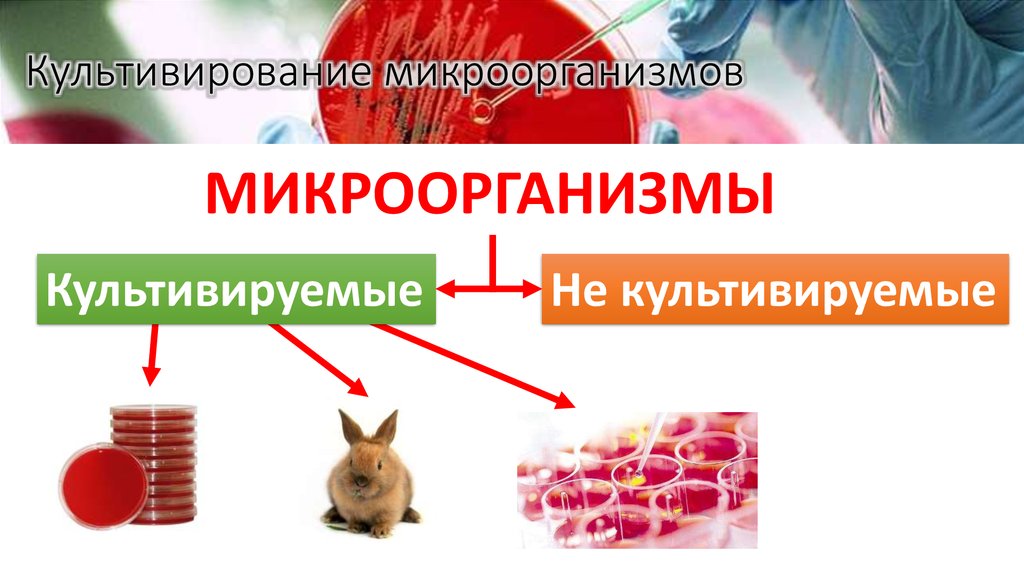
Культивирование микроорганизмов
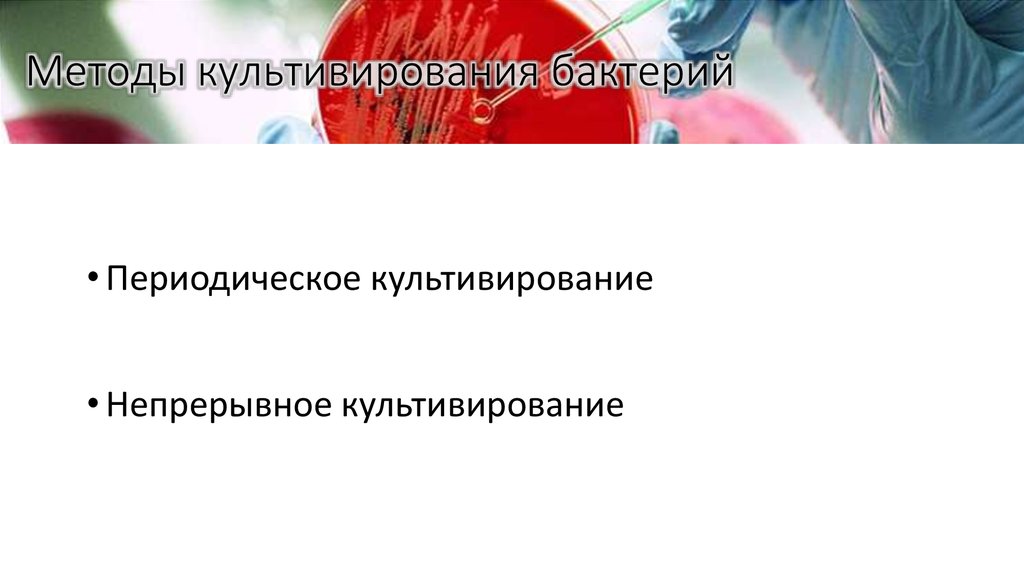
Методы культивирования бактерий
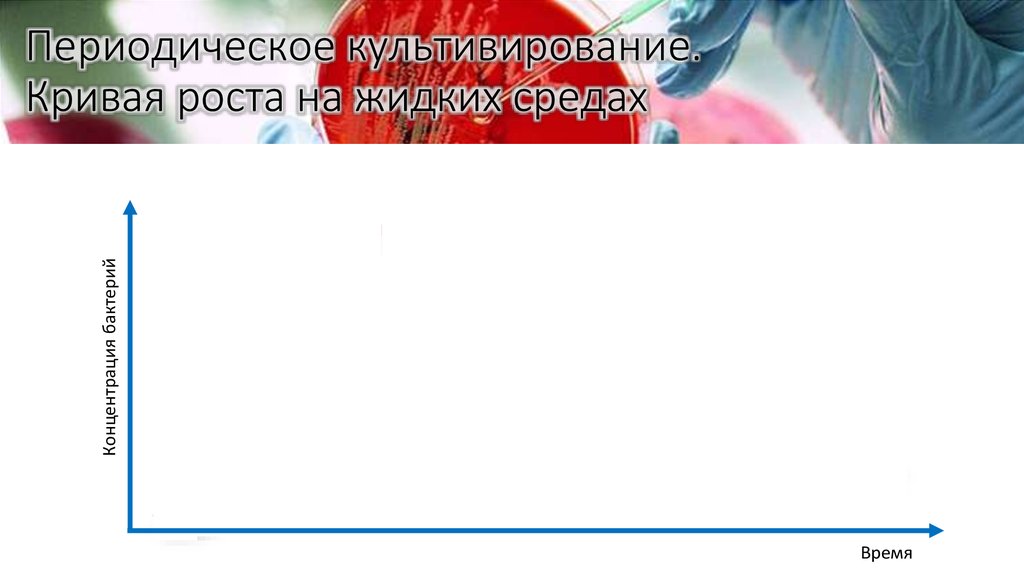
Периодическое культивирование. Кривая роста на жидких средах
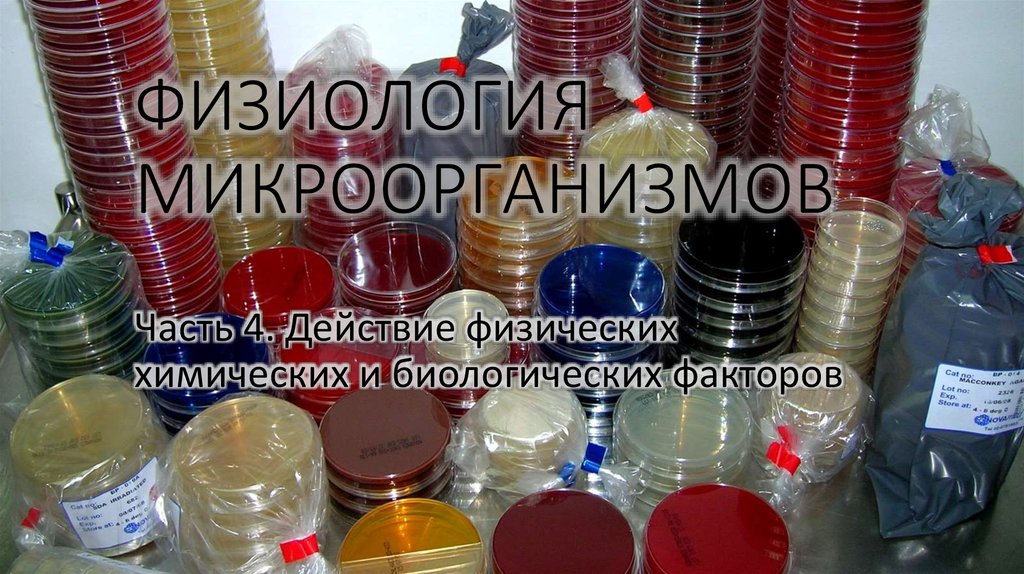
ФИЗИОЛОГИЯ МИКРООРГАНИЗМОВ
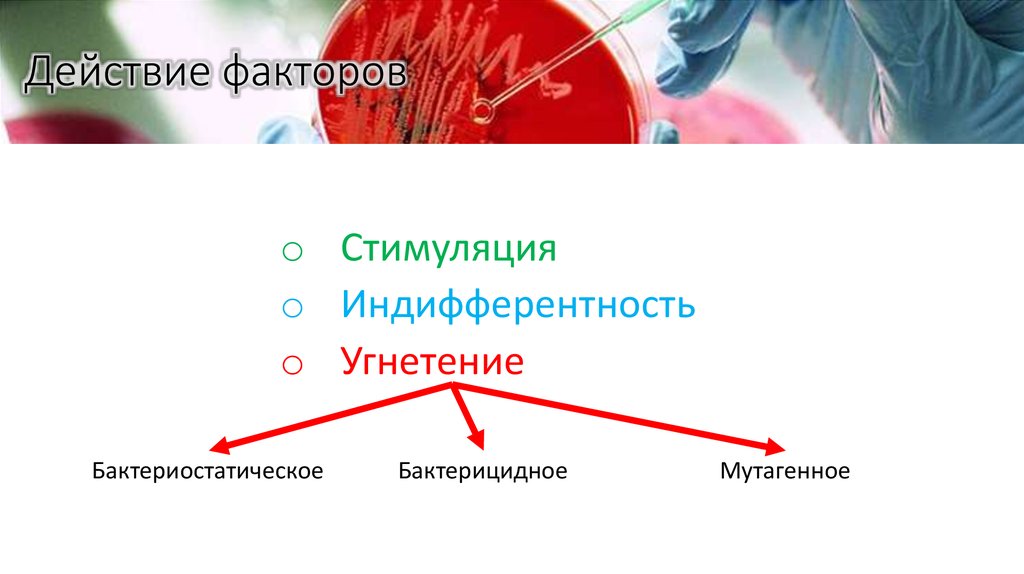
Действие факторов
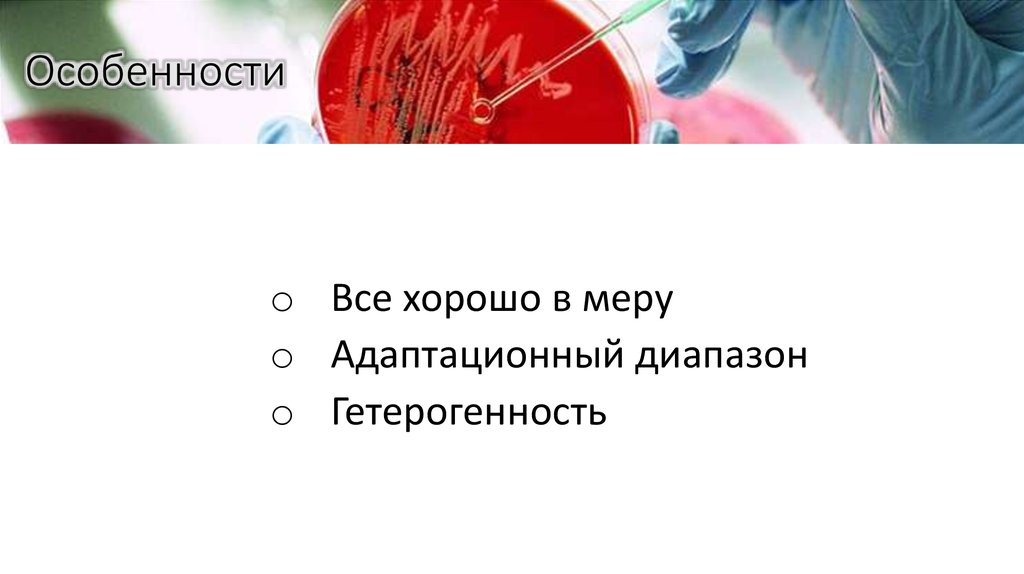
Особенности
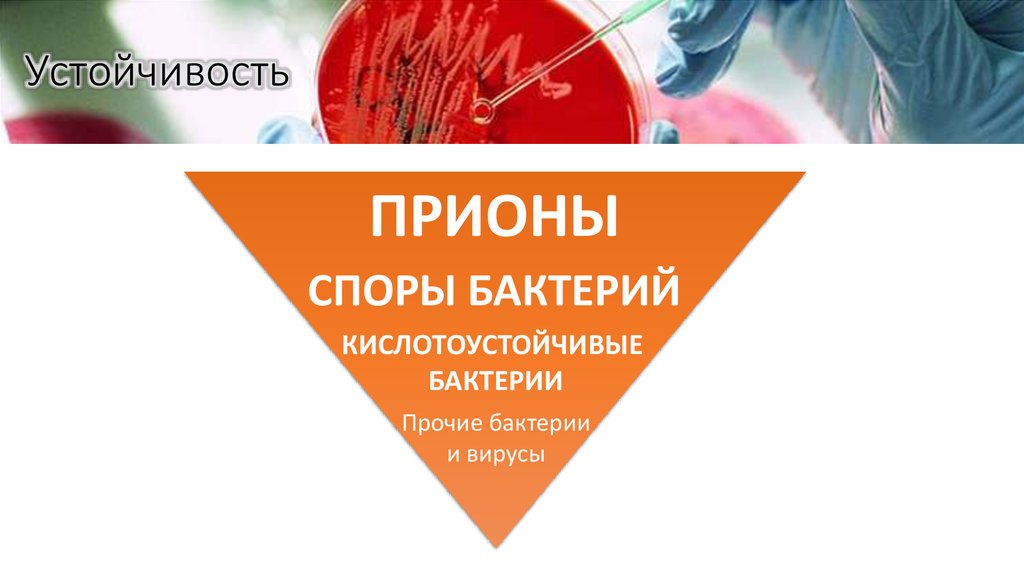
Устойчивость
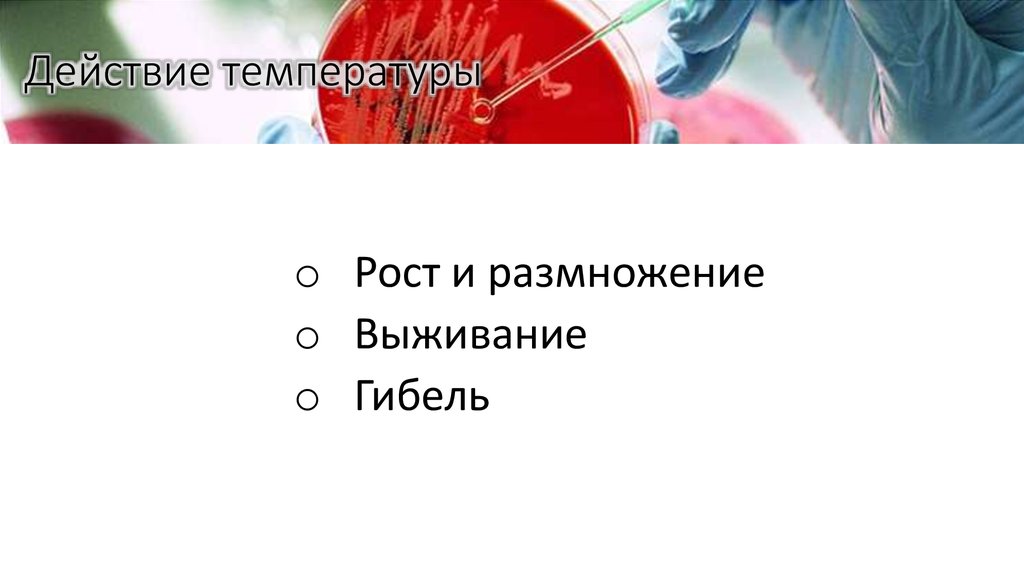
Действие температуры
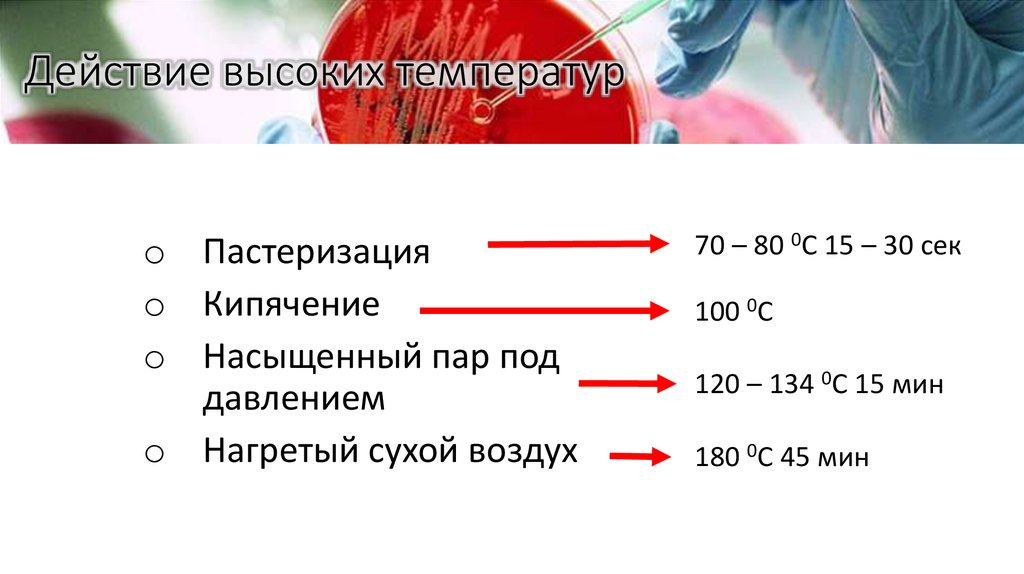
Действие высоких температур
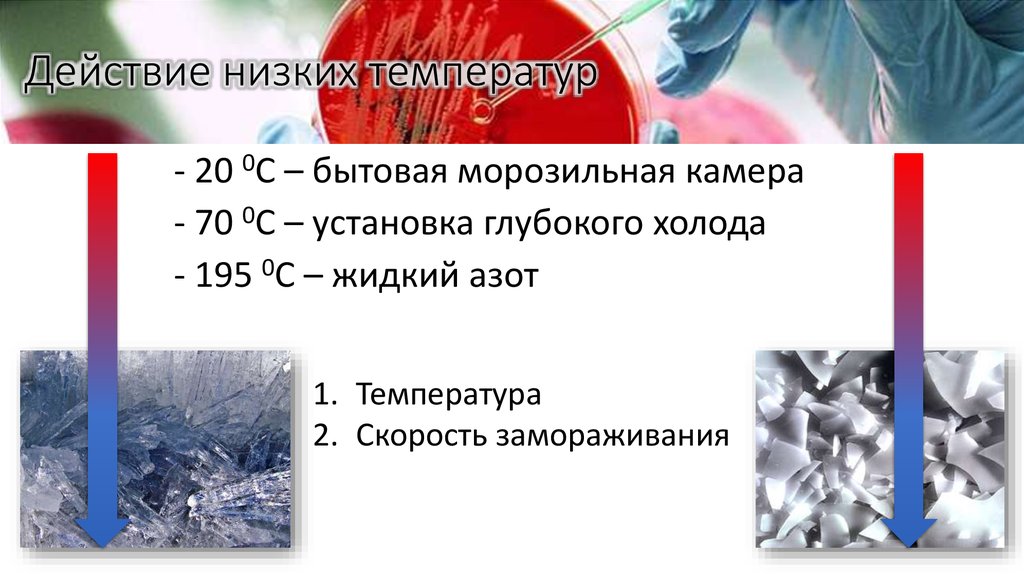
Действие низких температур
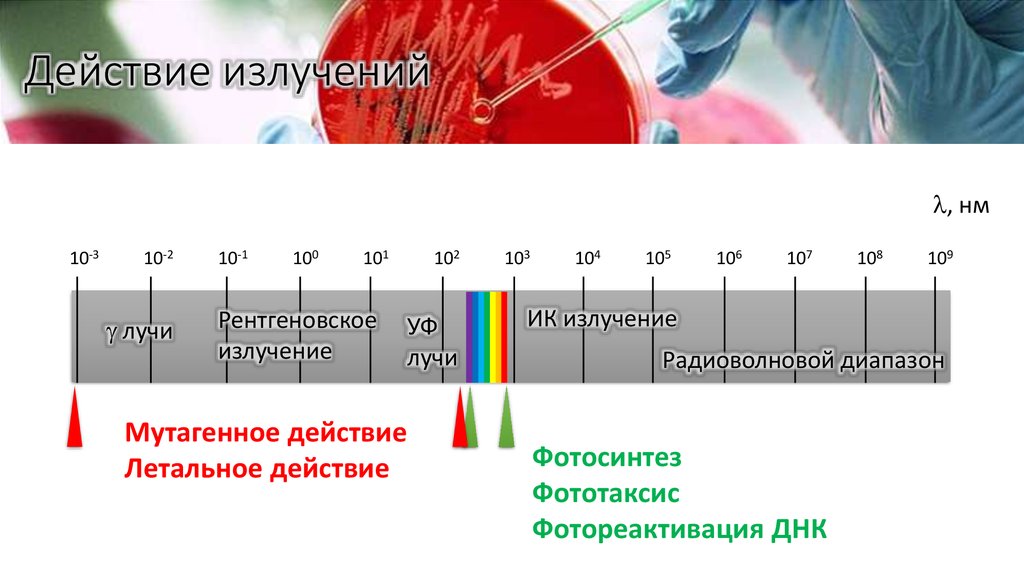
Действие излучений
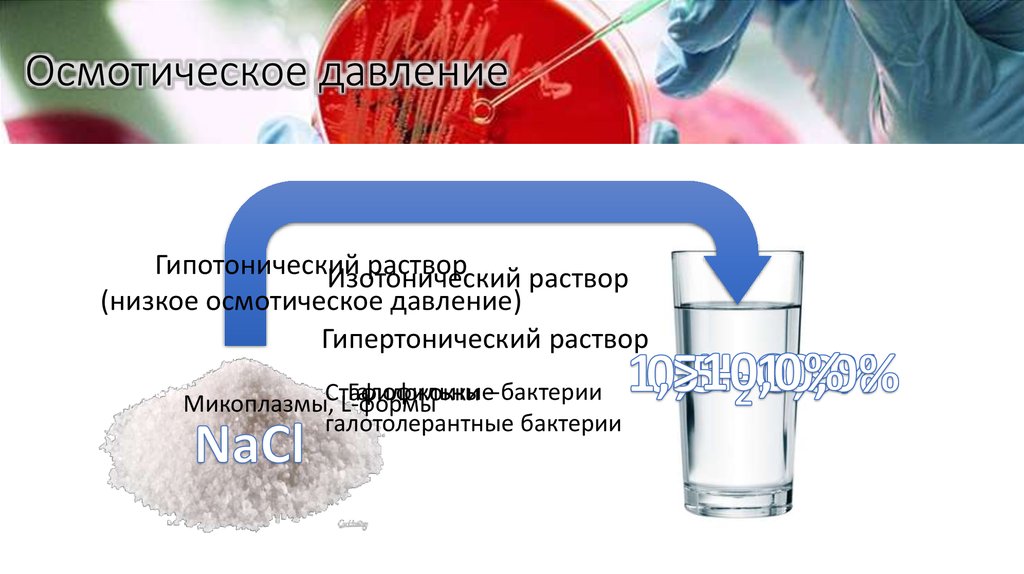
Осмотическое давление
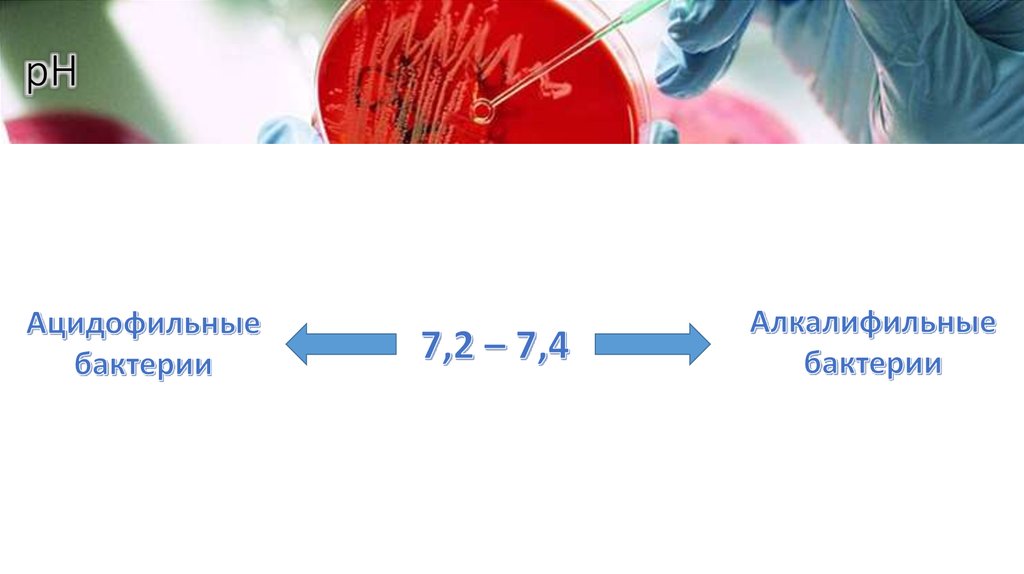
рН
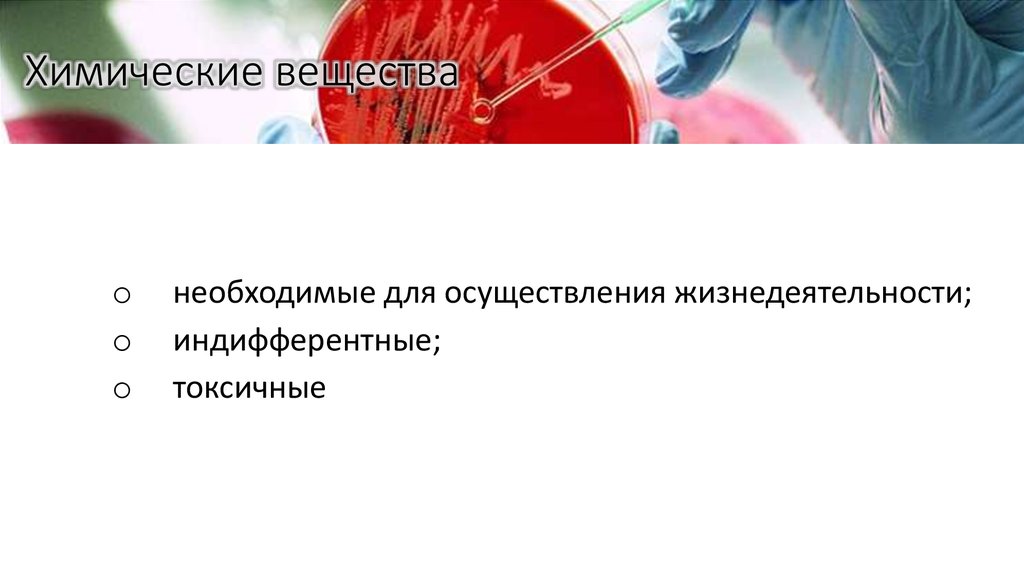
Химические вещества
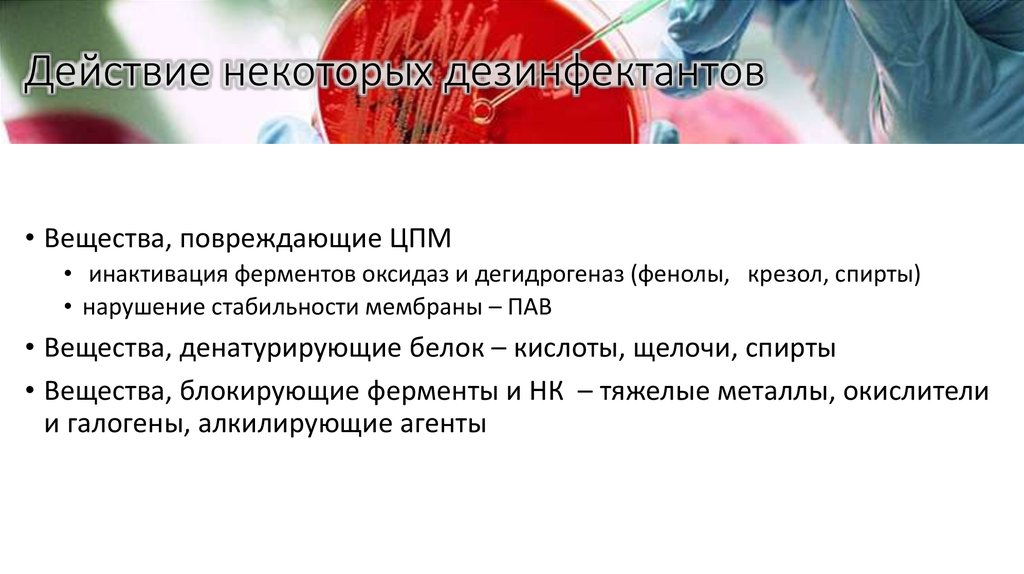
Действие некоторых дезинфектантов

Похожие презентации:
Физиология микроорганизмов. Таксономия. (Часть 2)
1. ФИЗИОЛОГИЯ МИКРООРГАНИЗМОВ
Часть 2. Таксономия2. Ключевые понятия
o Таксономия - наука о многообразии и взаимосвязях междуорганизмами.
Одна из задач - распределение (классификация)
множества организмов по группам ( таксонам )
o Номенклатура - раздел таксономии, определяющий правила
присвоения наименований описанным организмам
o Идентификация - установление тождественности неизвестного
объекта известному на основании совпадения признаков
3. Идентификация
4. Ключевые понятия.
o Чистая культурасовокупность микроорганизмов
одного вида на питательной среде.
o Штамм
чистая культура , выделенная из
определенного источника в
определенный момент времени.
5. Таксономия Карла Линея
Микроорганизмы неклассифицируются
ХАОС
6. Таксономия сегодня
НадцарствоЦарство
Порядок
Класс
Семейство
Род
Вид
Eucariota
Fungi
Protozoa
Candida
Candida
albicans
Trichomonas
Trichomonas
vaginalis
Procariota
Eubacteria
Escherichia
Escherichia
coli
Vira
Influenza virus
7. ФИЗИОЛОГИЯ МИКРООРГАНИЗМОВ
Часть 3. Рост и размножение8. Ключевые понятия
o Рост клетки – это координированное увеличение всехклеточных компонентов и структур, ведущее к увеличению
биомассы.
o Размножение – увеличение числа клеток в популяции.
9. Размножение микроорганизмов
ProcariotaАмитоз
a. Перегородка
b. Перетяжка
Eucariota
Митоз
Амитоз
• Почкование
• Шизогония
Vira
Дизъюнктивная
(разобщенная)
репродукция
10. Культивирование микроорганизмов
МИКРООРГАНИЗМЫКультивируемые
Не культивируемые
11. Рост на жидких и плотных средах
Луи ПастерLouis Pasteur
27.12.1822 – 28.09.1895
Ангелина Фанни Гисс
Angelina Funny Hess
22.06.1850 – 01.12.1934
Генрих Герман Роберт Кох
Heinrich Hermann Robert Koch
11.12.1843 – 27.05.1910
12. Методы культивирования бактерий
• Периодическое культивирование• Непрерывное культивирование
13. Периодическое культивирование. Кривая роста на жидких средах
Концентрация бактерийПериодическое культивирование.
Кривая роста на жидких средах
Время
14. Непрерывное культивирование
Управление:oХемостат
oТурбидостат
15. ФИЗИОЛОГИЯ МИКРООРГАНИЗМОВ
Часть 4. Действие физическиххимических и биологических факторов
16. Действие факторов
o Стимуляцияo Индифферентность
o Угнетение
Бактериостатическое
Бактерицидное
Мутагенное
17. Особенности
o Все хорошо в меруo Адаптационный диапазон
o Гетерогенность
18. Устойчивость
ПРИОНЫСПОРЫ БАКТЕРИЙ
КИСЛОТОУСТОЙЧИВЫЕ
БАКТЕРИИ
Прочие бактерии
и вирусы
19. Действие температуры
o Рост и размножениеo Выживание
o Гибель
20.
Вулканы, гейзеры…Умеренный пояс
100 – 300 ° С
Среднегодовая температура почвы 12 оС
Техногенные объекты…
Мировой океан
- 150 – 1000 ° С
90% вод - температура ниже 5°
21. Диапазоны роста
Yersinia pestis-10
0
10
20
30
40
50
60
70
80
90
100
Экстремальные термофилы
«Черные курильщики»
Психрофилы
Глубина – 4000 м
Мезофилы Термофилы
Давление > 300 атм.
Температура > 300 0C
22. Действие высоких температур
o Пастеризацияo Кипячение
o Насыщенный пар под
давлением
o Нагретый сухой воздух
70 – 80 0С 15 – 30 сек
100 0С
120 – 134 0С 15 мин
180 0С 45 мин
23. Действие низких температур
- 20 0C – бытовая морозильная камера- 70 0C – установка глубокого холода
- 195 0C – жидкий азот
24. Действие низких температур
- 20 0C – бытовая морозильная камера- 70 0C – установка глубокого холода
- 195 0C – жидкий азот
1. Температура
2. Скорость замораживания
25. Лиофильная сушка
ВакуумЖидкий азот
Эталонные штаммы
26. Действие излучений
, нм10-3
10-2
лучи
10-1
100
101
Рентгеновское
излучение
102
УФ
лучи
Мутагенное действие
Летальное действие
103
104
105
106
107
108
109
ИК излучение
Радиоволновой диапазон
Фотосинтез
Фототаксис
Фотореактивация ДНК
27. Осмотическое давление
Гипотоническийраствор
Изотонический
раствор
(низкое осмотическое давление)
Гипертонический раствор
Галофильные– бактерии
Микоплазмы,Стафилококки
L-формы
галотолерантные бактерии
28. рН
29. Химические вещества
oo
o
необходимые для осуществления жизнедеятельности;
индифферентные;
токсичные
30. Токсичные вещества
o Дезинфектантыo Антисептики
o Химиопрепараты
31. Действие некоторых дезинфектантов
• Вещества, повреждающие ЦПМ• инактивация ферментов оксидаз и дегидрогеназ (фенолы, крезол, спирты)
• нарушение стабильности мембраны – ПАВ
• Вещества, денатурирующие белок – кислоты, щелочи, спирты
• Вещества, блокирующие ферменты и НК – тяжелые металлы, окислители
и галогены, алкилирующие агенты

Биология
Биология








